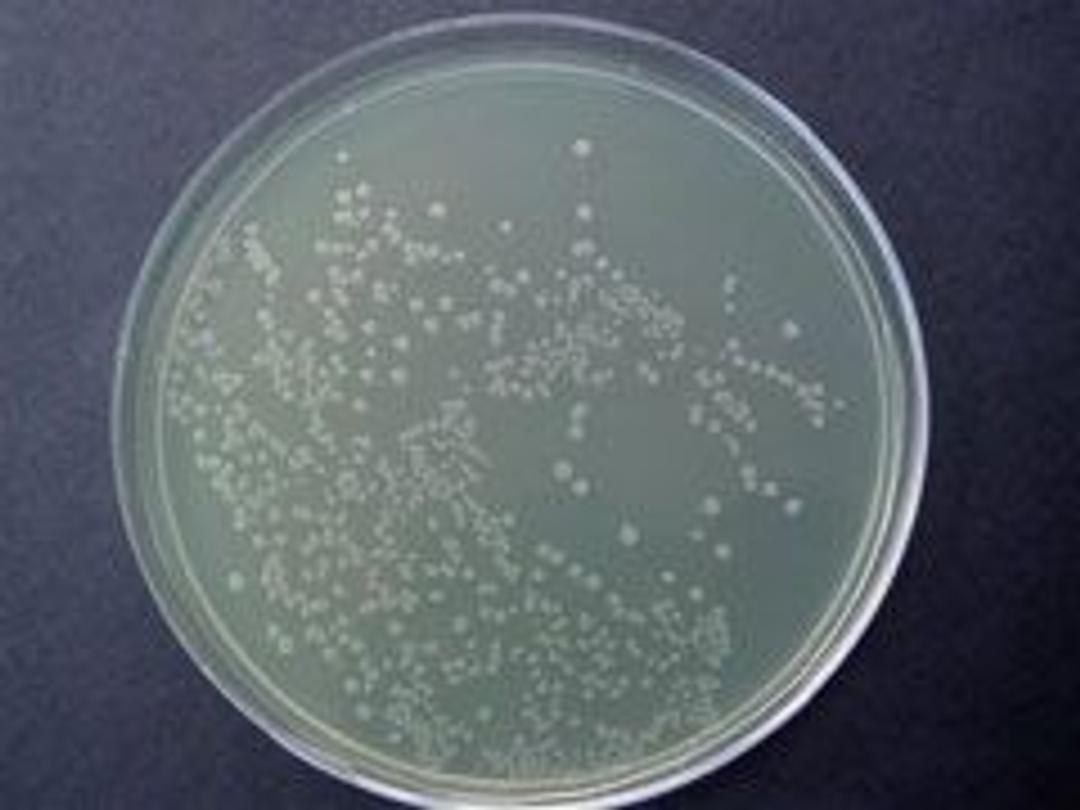

Smart Ampicillin™
Smart Ampicillin™ from Axygen Biosciences is a specially formulated Ampicillin antibiotic that is optimized for expression studies. Smart Ampicillin is superior to common antibiotics like Ampicillin, Carbenicillin and Methicillin. These regular antibiotics are degraded by enzymes secreted by bacteria over time and the result is the undesirable appearance of satellite or non-recombinant colonies. Smart Ampicillin is specially…

The supplier does not provide quotations for this product through SelectScience. You can search for similar products in our Product Directory.
Smart Ampicillin™ from Axygen Biosciences is a specially formulated Ampicillin antibiotic that is optimized for expression studies.
Smart Ampicillin is superior to common antibiotics like Ampicillin, Carbenicillin and Methicillin. These regular antibiotics are degraded by enzymes secreted by bacteria over time and the result is the undesirable appearance of satellite or non-recombinant colonies. Smart Ampicillin is specially formulated to overcome this bacterial enzyme degradation and hence present you with Satellite free recombinant colonies for an extended period of time.
Features of Smart Ampicillin:
• Smart Ampicillin is optimized for expression studies ensuring perfect recombinant colonies.
• No appearance of satellite colonies after transformation.
• Smart Ampicillin is stronger than traditional antibiotics.
• Better suited for downstream analysis such as colony counting, picking, etc.
• Convenient pre-made solutions of 1ml at 1,000x concentrate.
• Suitable for liquid cultures or plates.